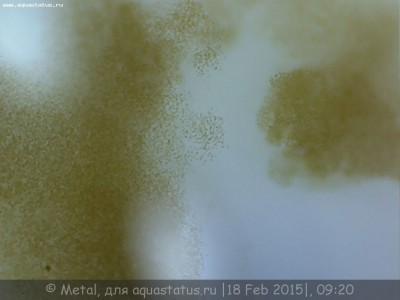
Помогите подобрать микроскоп по аквариумистике 21 Июль 2018 08:59 третье Помогите подобрать микроскоп по аквариумистике 21 Июль 2018 08:59 третье

| Автор |
Сообщение |
|
Danchik L
|
|
Регистрация: 20 июл 2018 Посты: 5
Google+:
|
Здравствуйте, интересуюсь морской аквариумистикой для просмотра и определения однокл.огранизмов и т.д. и следовательно предпочтение чтобы изображение передавалась на ПК или на флешку, возможно с экраном...но я так понял он дорог(( бюджет около 6000грн
Спасибо!
|
|
|
|
|
|
|
Andrey Moskvin
|
|
Регистрация: 01 ноя 2013 Посты: 6233 Откуда: Запорожье
Vk:
Facebook:
Google+:
|
Danchik L писал(а): Здравствуйте, интересуюсь морской аквариумистикой для просмотра и определения однокл.огранизмов и т.д. и следовательно предпочтение чтобы изображение передавалась на ПК или на флешку, возможно с экраном...но я так понял он дорог(( бюджет около 6000грн
Спасибо! Я так понял, вам нужен биологический микроскоп и окулярная камера. Ваши одноклеточные видно на светлом поле, или нужно темное поле и может даже фазовый контраст?
_________________ Предпродажные и после продажные консультации. Сертифицированный партнер AstroScope #110907. Delta Optical-GSO Dobson 10" F/5 M-CRF, SW 1206 на DO GSO ATZ, Arsenal ED80/560, Delta Optical 25x100, Celestron Giant 20x80, Minolta Standard EWA 10x50
|
|
|
|
|
|
|
Игорь Астроскоп
|
|
Регистрация: 20 июн 2011 Посты: 7352
Vk:
Facebook:
Google+:
|
Danchik L писал(а): интересуюсь морской аквариумистикой для просмотра и определения однокл.огранизмов и Рекомендую привести пример - какую картинку Вы ожидаете! Тогда и оборудование будет подобрано быстрее и дешевле 
|
|
|
|
|
|
|
Danchik L
|
|
Регистрация: 20 июл 2018 Посты: 5
Google+:
|
Спасибо за ответы) к сожалению, я не разбираюсь в микроскопах и не могу ответить что мне нужно из характеристик прибора... где-то читал что лучше выбирать биологический и объектив ахроматический....) Повторюсь, для определения клеток/бактерий в морской воде к примеру по фото/видео:
Комментарий к файлу: Диатомовые
 Просмотров: 4603
Комментарий к файлу: Цианобактерии
 Просмотров: 4603
Комментарий к файлу: Дино
Просмотров: 4603
|
Последний раз редактировалось Danchik L 21.07.2018 09:11, всего редактировалось 5 раз(а).
|
|
|
|
|
|
|
Danchik L
|
|
Регистрация: 20 июл 2018 Посты: 5
Google+:
|
|
|
|
|
|
|
Михаил Астроскоп
|
|
Регистрация: 05 май 2014 Посты: 1612 Откуда: Харьков
Vk:
Facebook:
Google+:
|
|
|
|
|
|
|
Danchik L
|
|
Регистрация: 20 июл 2018 Посты: 5
Google+:
|
|
|
|
|
|
|
Andrey Moskvin
|
|
Регистрация: 01 ноя 2013 Посты: 6233 Откуда: Запорожье
Vk:
Facebook:
Google+:
|
|
|
|
|
|
|
Михаил Астроскоп
|
|
Регистрация: 05 май 2014 Посты: 1612 Откуда: Харьков
Vk:
Facebook:
Google+:
|
Danchik L писал(а): или уже более интересный экземпляр...но нужно докупать тогда камеру?: Да. Этот экземпляр конечно интереснее, но камеру действительно подкупать отдельно.
|
|
|
|
|
|
|
Danchik L
|
|
Регистрация: 20 июл 2018 Посты: 5
Google+:
|
Всем Спасибо за ответы:) Михаил Астроскоп писал(а): Да. Этот экземпляр конечно интереснее, но камеру действительно подкупать отдельно. подбор камеры только по аналогичному бренду или иные также подходят? если в общем, то на какие критерии характеристик присматриваться?
|
|
|
|
|
|
|
|